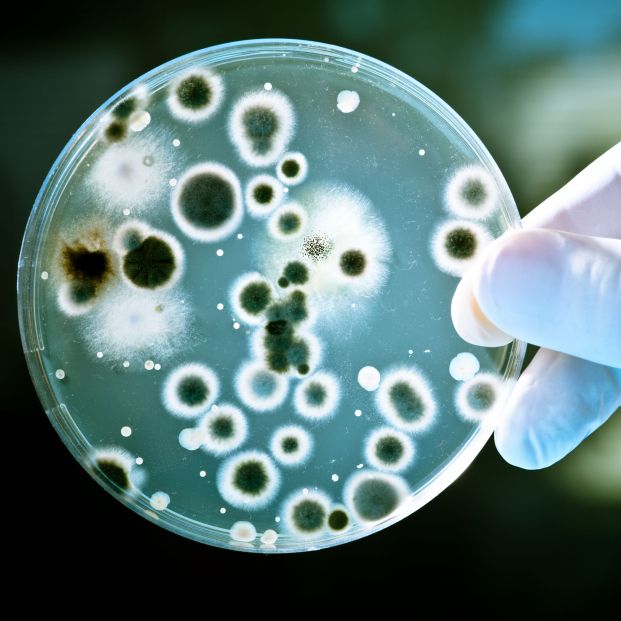
foto bacterias foto bacterias

La resistencia a los antibióticos: un problema que puede ser peor que la pandemia
Descubren que algunas aves domésticas en contacto con el humano ya son resistentes
Los equipos de investigación de la Universidad de Cádiz (UCA), la Estación Biológica de Doñana (EBD-CSIC) y la Universidad de Sevilla (US), en colaboración con el Instituto Catalán de Investigación del Agua (ICRA), han detectado la presencia de genes más resistentes a antibióticos en especies de aves en espacios más humanizados.
La investigadora de la UCA y autora principal del estudio, Dayana Jarma, ha explicado que "se ha encontrado que las gaviotas sombría y las cigüeñas blancas portan una mayor resistencia a antibióticos que los gansos y las grullas comunes".
"La resistencia a antibióticos es un fenómeno común en las bacterias, pero la tasa con la que se produce es mucho mayor ahora, y poco se sabe sobre cómo evoluciona en la fauna silvestre", ha indicado la investigadora.
También se ha testeado la diversidad microbiana de las heces, para detectar géneros y especies que pueden convertirse en agentes infecciosos. "Al coincidir ambos factores, genes inmunes a antibióticos y potenciales patógenos para el ser humano, el riesgo que representan para la salud se incrementa", ha añadido Jarma.
"El problema no está en las aves sino en el mal uso y abuso que se está haciendo de los antibióticos". "Estos resultados sugieren que la exposición de la fauna silvestre a las aguas residuales --donde hay residuos de antibióticos en abundancia-- facilita que se adquieran dichas resistencias", ha apostillado.
La investigación profundiza en los mecanismos de diseminación de resistencia a antibióticos en el ambiente. Jarma ha explicado que "confirma que las aves migratorias estudiadas son vehículos de diseminación de bacterias patógenas, muchas resistentes a antibióticos".
Fuentes de resistencia
En estos momentos, el equipo investiga si la resistencia a antibióticos en la gaviota sombría varía entre diferentes hábitats y el por qué de estas variaciones. Así, estudiarán la resistencia de las bacterias que porta este ave en humedales, playas o vertederos. Así los expertos detectarán fuentes de resistencia, lugares donde existen más bacterias resistentes a antibióticos y dónde hay una mayor proporción de genes de resistencia.
El objetivo es analizar la comunidad bacteriana presente en los hábitats donde el ave descansa o se alimenta mediante técnicas de biología molecular.
